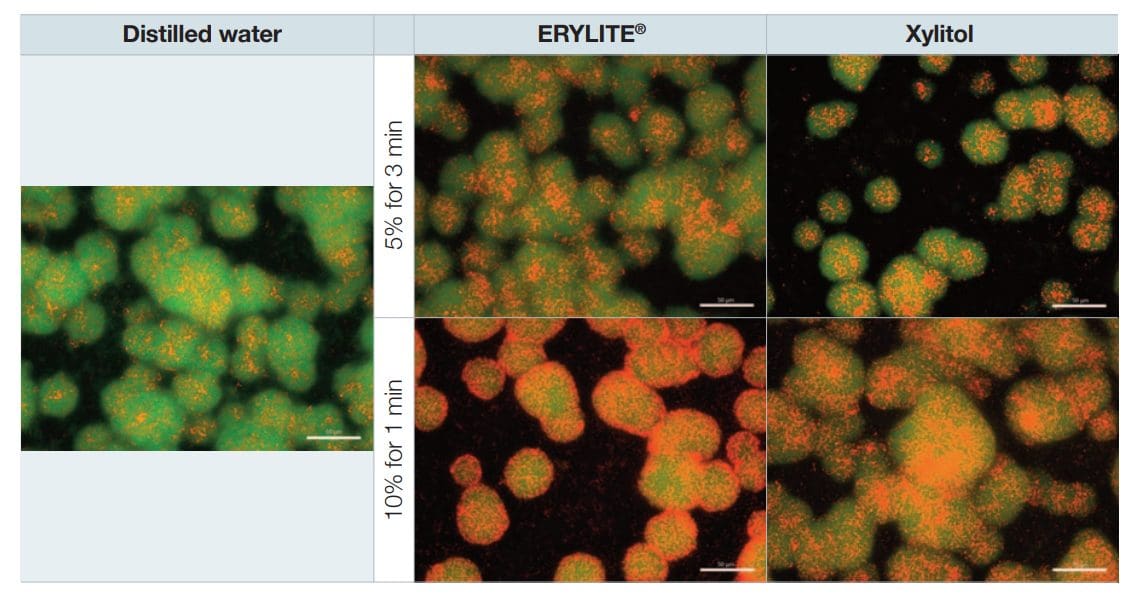

Introduction
A broad smile makes a good first impression in every face-to-face encounters and plays a vital role in communication. Not surprisingly, healthy teeth are perceived as an important positive visual trait. Several studies have linked oral health with social and emotional well-being.[1,2] However, in our fast-paced society, people often have little opportunity to brush their teeth frequently or evaluate the impact of the food they consume on their dental health. This increases the need for products and ingredients which support and prolong the effect of oral care products.
The most commonly used products are toothpastes and mouthwashes. Newer formats such as tooth tablets or powders follow the same principle, being designed to remove bacteria, plaque and food residues either mechanically or by rinsing. The substance commonly referred to as plaque or oral biofilm is actually an agglomeration of microorganisms, usually bacteria, embedded in and mechanically protected by a matrix of polymers.[3] The formation of such a biofilm starts when bacteria gain initial adhesion on a pellicle. This pellicle serves as an anchor point on the surface of the tooth: the bacteria then start to grow and multiply, they communicate with each other, and they secrete glycoproteins, resulting in a biofilm. Biofilms have been reported to be associated with dental caries, periodontal disease and gingival conditions.[4] It is therefore a common aim of oral care products to reduce the level of biofilm in the oral cavity. The most obvious way to do this is by mechanical removal (brushing), but supporting ingredients that impact bacterial growth can also contribute to this objective.
Different bacterial species are present in a healthy oral microbiome. This is not dangerous per se, nor will it cause any pathological condition as long as the bacteria present are in homeostasis. However, if conditions in this environment change – for example, increased sugar availability after eating – certain species will respond to their new environment differently from others. Clinical studies have shown that individuals with dental caries also demonstrate increased proportions of acidogenic and aciduric bacteria (especially mutans streptococci and lactobacilli), which are capable of demineralising enamel.[5] These bacteria do so by metabolising dietary sugars to acid, which decreases the local pH, generating an acidic environment which is favourable for their growth, but disadvantageous for other species.
Reducing sugar consumption and applying oral care products with ingredients which inhibit the growth of unwanted bacteria are therefore two of the main pillars in oral biofilm prophylaxis. One class of ingredients which have proven beneficial are polyols such as sorbitol, xylitol and erythritol. This study presents evidence of the positive impact of erythritol on oral biofilm in realistic scenarios.
ERYLITE® – general properties
Erythritol (brand name ERYLITE®) is a white, crystalline and odourless product widely used in food, beverages and personal care products. It is a natural sweetnener approximately 60% as sweet as sugar. It can be considered natural because it occurs in nature and the production process is based on a non-genetically modified yeast fermentation of plant-based raw materials. Erythritol is a four-carbon sugar alcohol (polyol) with a very low molecular weight (122 g/mol) and is characterised by unique metabolic attributes: after consumption, the vast majority is absorbed in the small intestine, and is therefore excreted in the urine instead of being metabolised. Consequently, it is tolerated very well by the digestive system. Furthermore, it delivers no calories, is non-glycaemic and does not trigger an insulin response.
ERYLITE® – a sustainable ingredient
The main raw material for ERYLITE® production is glucose derived from corn. Upon request, the glucose can be supplied by farmers committed to sustainable agriculture as verified by SAI Platform’s farm sustainability assessment (FSA).
- Jungbunzlauer is committed to the Science Based Targets initiative (SBTi) and sets targets to reduce greenhouse gas emissions in line with climate science – for example, by further improving the company’s energy management system.
- Jungbunzlauer regularly calculates product carbon footprints (PCFs) in collaboration with a certified and independent external partner (myclimate).
- The production plant for ERYLITE® is ISO 50001 certified and has implemented an energy management system focused on continuous improvement.
Benefits of ERYLITE® in oral care
When ERYLITE® is added to oral care products, its natural sweetness helps improve consumer perception by improving the taste of the product. It also allows formulation of innovative products with special cooling effects – e.g. toothpaste with crystals.[6]
In general, polyols are known for their non-cariogenic properties, since they cannot be metabolised by certain unwanted bacteria in the oral cavity. This is due to their molecular structure and the absence of reducing carbonyl groups, unlike sugars such as glucose or fructose. Polyols also reduce the growth of some bacteria which are associated with pathogenic conditions.[7,8] This is reflected in the statement by the European Food Safety Authority (EFSA), which recognises that the use of polyols as a sugar substitute in food products helps to maintain tooth mineralisation.[9]
While xylitol is probably the most prominent polyol used for oral health, an increasing number of recent studies have highlighted the potential of erythritol to act in the same way.[6] In vitro, erythritol was shown to have an impact via several pathways – these included bacterial gene expression,[10] bacterial metabolism[11] and accumulation of extracellular matrices.[11,12] Because of its small molecular size, erythritol was shown to readily penetrate biofilm, and therefore also has the potential to support the effect of antimicrobial compounds such as chlorhexidine.[13] In vivo, the application of erythritol resulted in a reduction of dental plaque, delayed the development of caries and reduced the overall occurrence of caries in a long-term study, which was also confirmed in a follow-up study.[14–16] De Cock et al. have published a review providing a broad overview of existing literature on relevant in vitro and in vivo studies, as well as clinical trials with erythritol.[17]
Erythritol also has other applications worthy of note, one of which is in tooth air polishing powders as used by dentists for professional prophylaxis. Over the last decade, air polishing with low-abrasive erythritol-based powder has become increasingly popular. This is a rapid procedure which achieves maximum cleaning performance and is more convenient for patients than traditional alternatives.[18]
Another application of erythritol is in oral care products for animals: Like humans, pets also suffer from bad breath and periodontal diseases. Thus, products to improve oral health in pets, such as dog chewing sticks containing erythritol, are becoming increasingly widely available. The literature shows that erythritol provides the same advantages for canines as it does for human oral health[19,20], and – in contrast to xylitol – erythritol is safe for use in animal care products, being non-toxic to dogs and other popular pets.[21,22]
To sum up, the literature shows that polyols in general and erythritol in particular have a positive impact on oral health, and specifically on biofilm formation. However, the setups of the various studies differ widely, and the results are not readily comparable. Past studies have often involved exposure to polyols over extended periods of several hours, which does not adequately reflect use in oral care products. Furthermore, many tests have included elevated polyol concentrations, which are difficult to achieve in the oral cavity with oral care products: this is due to factors such as space limitations or solubility limits in a full formulation. Our study therefore aimed to better consider these aspects, further demonstrating the potential of erythritol in oral care products.
Study design
Overall objectives of the study
The goal of the study was to compare the effects of erythritol and xylitol on biofilm growth of Streptococcus mutans in an in vitro model, using realistic exposure times and concentrations (figure 1). Each polyol was subjected to two tests. The first test aimed to create a scenario to mimic tooth brushing, with a concentration of erythritol in toothpaste or tooth tablets of 10 wt%, 1:2 dilution by saliva and a typical tooth brushing time of 3 min. The second scenario aimed to mimic mouthwashing, with a 10% concentration of polyol in the mouthwash product, no dilution and a mouth rinsing time of 1 min. In both tests, sucrose was also supplied after treatment with polyols to mimic consumption of detrimental cariogenic substances after brushing or mouthwashing. The results were evaluated using the following methods:
- Plate counting of colony forming units (CFUs) to determine bacterial viability.
- Luminescence assay to measure adenosine triphosphate (ATP) as an indicator of metabolic activity of the bacteria.
- Fluorescence microscopy to check for bacterial membrane integrity.
Figure 1: Treatment scenarios with different exposure times and polyol concentrations
Mouthwash scenario
Concentration of polyol: 10%
Toothpaste scenario
Concentration of polyol: 5%
Materials
All trials were performed by the Fraunhofer Institute for Microstructure of Materials and Systems (IMWS) (Halle an der Saale, Germany). The gram-positive bacterial strain S. mutans DSM-20523 was chosen as the model organism and the causative agent for the dental biofilm. Polymethylmethacrylate (PMMA) discs with a slight abrasion on one side were used as a substrate for biofilm growth. Treatment solutions were freshly prepared in distilled water immediately prior to application. ERYLITE® was provided by Jungbunzlauer. Xylitol, Todd Hewitt broth, maximum recovery diluent (MRD) and Tween® 80 were obtained from Carl Roth (Karlsruhe, Germany). Sucrose and fluoromount mounting media were obtained from Sigma-Aldrich (St. Louis, MO, USA).
Experimental procedure
To prepare the model biofilm, S. mutans was cultivated for 24 h and the cell concentration was adjusted to an optical density (OD600) of 0.1. The cell suspension was diluted 200-fold using Todd Hewitt broth with 1% sucrose to ensure a supply of nutrients for biofilm growth as suggested by Loimaranta et al.[23] 1 mL of this inoculum was pipetted into each well of a 24-well plate carrying the PMMA discs and incubated for 16 h at 37 °C to allow the biofilm to settle and establish. The supernatant was then removed, and the discs were rinsed with MRD solution and transferred to a new well for treatment application.
Reflecting the different application scenarios as described above, the following treatments were applied. Each test used a volume of 1 mL and was performed in triplicates:
- Negative control (distilled water).
- 5% erythritol for 3 min (tooth brushing scenario).
- 5% xylitol for 3 min (tooth brushing scenario).
- 10% erythritol for 1 min (mouthwash scenario).
- 10% xylitol for 1 min (mouthwash scenario.
After the relevant exposure times, the treatment solution was removed and replaced by 1 mL of Todd Hewitt broth with 1% sucrose to mimic sugar consumption after brushing/mouthwashing and thus renew the nutrient supply to the bacterial biofilm. After incubation at 37°C for 3 hours, the samples were rinsed again with MRD and transferred to a new well. The biofilm was mechanically removed from the surface of the PMMA discs with a cotton swab, and the cells were resuspended in an MRD solution with 0.1% Tween® 80 by vortexing.
Quantitative evaluation by viable plate counting
Colony-forming units were determined from the recovered cell suspension by undertaking a 10-fold serial dilution, plating the diluted suspension on plate count agar and incubating at 37°C for 72 h. Plates were prepared in triplicates. Colonies were counted from photographs using the Cell F software package (Olympus, Germany). All plates with between 10 and 400 colonies were included when calculating CFUs.
Qualitative evaluation by fluorescence microscopy
After rinsing the biofilm grown on the PMMA discs, cell staining was performed by applying Syto® 9 and propidium iodide dyes (LIVE/DEAD® BacLight Bacterial Viability Kit, Thermo Fisher Scientific) to the wells and incubating according to the manufacturer’s instructions. These dyes selectively penetrate bacterial cells depending on their membrane integrity. As a result, cells with damaged membranes appear red under a fluorescence microscope, whereas cells with intact cell membranes appear green. The samples were mounted on slides using fluoromount media and analysed using a BZ-X fluorescence microscope (Keyence, Germany) at 40x magnification.
Quantitative evaluation of metabolic activity
Biofilm samples were cultivated and treated with the test solutions as described above. After rinsing the PMMA discs, the reverse side of the discs was wiped with a paper towel and they were transferred with the biofilm side down to a fresh well containing MRD and reagents from the BacTiter-Glo™ Microbial Cell Viability Assay kit (Promega, Madison, WI, USA). Samples were incubated and agitated for 12 min at room temperature. The BacTiter-Glo™ reagents promote cell lysis to liberate the ATP present in the cell at a given instant, and generate a luminescent signal which is proportional to the amount of ATP present. A calibration curve was prepared from an ATP standard. After incubation, samples were transferred in duplicate to an opaque well plate and luminescence was measured (FLUOstar® Omega, software version 570R2, BMG Labtech, Ortenberg, Germany).
Statistical analysis
Statistical analyses were performed by one-way analysis of variance (ANOVA), with post-hoc Tukey’s tests and Levene’s tests to analyse homogeneity of variance (Origin2020, Origin Lab Corporation Company, Northampton, MA, USA). The level of significance α was set at 0.05.
Results and discussion
All experimental scenarios confirmed that erythritol and xylitol inhibit the growth of S. mutans. Figure 2 shows the number of CFUs in samples treated with polyols for each of the different application scenarios. As the gold standard of viable cell analysis, colony counting gave a reliable insight into the ability of S. mutans to proliferate.
All polyol treatments resulted in a statistically significant reduction. In the case of ERYLITE® (exposure for 1 min), the
CFUs were reduced from 8.15 x 108 in the control to 4.62 x 108, a 53% reduction in cell viability. There was no
statistically significant difference in growth inhibition between the treatments.
Figure 2: Colony forming units (CFUs) in biofilm after treatment with different polyols in different exposure scenarios.

| Viable cell concentration (CFUs/sample) | Distilled water | 5% ERYLITE® 3 min. | 5% Xylitol 3 min. | 10% ERYLITE® 1 min. | 10% Xylitol 1 min. |
| Mean | 8.15E+08 | 4.63E+08 | 5.35E+08 | 4.62E+08 | 4.60E+08 |
| Standard deviation | 1.21E+08 | 8.52E+07 | 5.09E+07 | 4.14E+07 | 4.09E+07 |
As a complementary method, the luminescence assay – based on detection of ATP – fully backed up the results obtained by colony counting. Figure 3 shows how the different treatment scenarios reduced the ATP content from 97.3 pmol in the control to as low as 68.4 pmol (10% erythritol for 1 min). All polyol treatments resulted in a statistically significant reduction of the ATP content compared to the control, but there was no statistically significant difference between the treatments.
Figure 3: Levels of adenosine triphosphate (ATP) detected after treatment of biofilm with polyols at different concentrations and with different exposure times.

| Viable cell concentration (CFUs/sample) | Distilled water | 5% ERYLITE® 3 min. | 5% Xylitol 3 min. | 10% ERYLITE® 1 min. | 10% Xylitol 1 min. |
| Mean | 97.28 | 71.62 | 76.07 | 68.41 | 71.32 |
| Standard deviation | 9.04 | 10.42 | 6.34 | 4.18 | 6.68 |
Qualitative analysis was undertaken by examining the samples using a fluorescence microscope after live/dead staining. As shown in figure 4, the proportion of red-stained cells – i.e. cells with compromised membranes – was larger in the samples treated with polyols than in the control. Although not significant, there was a slight trend indicating a dose-dependent effect.
Figure 4: Images under a fluorescence microscope after live/dead staining of biofilm samples (40x magnification). Dead cells appear red, live cells appear green. Scale bars indicate 50 µm.
The tested polyol concentrations of 5% and 10% were well within the range of concentrations previously tested in the scientific literature and led to comparable reductions in cell viability. For example, Loimaranta et al. observed a reduction in CFUs of S. mutans in the range of one order of magnitude (observed reduction: 90%) when the growth medium included 5% erythritol or xylitol.[23] Kõljalg et al. noted a growth inhibition of S. mutans of 30–50% with 3.75–7% erythritol or xylitol.[24] Staszczyk et al. measured a growth inhibition in the same range (below one order of magnitude) with polyol concentrations of 5%.[25] Finally, Ghezelbash et al. observed a 68% and 71% reduction of S. mutans viability when using 4% xylitol and 4% erythritol, respectively.[12] Furthermore, it should be noted that strain-specific susceptibility to polyol treatment has been described in literature, implying that the potential benefit of applying erythritol and xylitol may depend on the patient’s pathogen profile.[7,24]
One notably different parameter in the present study is the short exposure time of the biofilm to the polyol treatments. In the studies cited above, growth curves were recorded in the continuous presence of polyols over a period of between 10 h[23] and 72 h.[25] Typical oral hygiene routines take between 30 sec and 1 min in the case of mouthwashing, or between 1 and 3 min for tooth brushing. Therefore, an experiment in which the biofilm is exposed to polyols over several hours does not adequately reflect reality. To the best of our knowledge, our results are the first to show that erythritol and xylitol provide significant benefits even over very short contact times of as little as 1 min.
A proposed mode of action by which erythritol and xylitol may impede biofilm formation is the reduction of exopolysaccharide production, thus causing the biofilm to adhere less tightly.[10–12,23] This may result in easier removal of the biofilm during rinsing, which would account for the reduced cell count and lower levels of ATP detected. In contrast to harsh antimicrobials, polyols are more gentle on beneficial oral microflora, which plays an important role in oral and general health. In fact, a long-term study investigating the composition of the oral microbiomes of children after regular consumption of polyols showed that erythritol led to a significant change in the microbiome, resulting in lower prevalence of caries-related mutans streptococci.[26] Finally, a recent study investigated the biocompatibility of a toothpaste containing erythritol and xylitol, confirming its particular mildness on cells of the oral mucosa; only a small number of tested products on the market met this criterion.[27]
Conclusion
The present study demonstrates the effectiveness of erythritol in an experimental setup focusing on realistic exposure times and concentrations. Growth inhibition of oral disease-related bacteria was proven by viable plate counting, fluorescence microscopy and a luminescence assay. The performance of erythritol was shown to be comparable with that of xylitol. Erythritol is thus suitable for application in a variety of product formats for oral health, such as mouthwashes, toothpastes, gels and tablets. It is a valuable natural ingredient, which not only adds sweetness but also has a positive impact on oral biofilms.
Interested in developing your next oral care formulation?
Our technical experts support customers in translating scientific insights into effective product applications.
If you’d like guidance, data, or formulation support, we’re here to help.
References
[1] L. M. Jamieson, Y. C. Paradies, W. Gunthorpe, S. J. Cairney, S. M. Sayers, Oral health and social and emotional well-being in a birth cohort of Aboriginal Australian young adults, BMC Public Health 2011, 11, 1–11.
[2] S. Kisely, No mental health without oral health, Can. J. Psychiatry 2016, 61, 277–282.
[3] P. D. Marsh, Dental plaque as a biofilm and a microbial community – implications for health and disease, BMC Oral Health 2006, 6, 1–7.
[4] S. Murakami, B. L. Mealey, A. Mariotti, I. L. C. Chapple, Dental plaque-induced gingival conditions, J. Periodontol. 2018, 89, S17–S27.
[5] P. D. Marsh, Microbiologic aspects of dental plaque and dental caries, Dent. Clin. North Am. 1999, 43, 599–614.
[6] T. Berninger, T. Bernsmeier, ERYLITE® Erythritol in oral care, FACTS Jungbunzlauer 2019.
[7] M. l Cannon, M. Merchant, W. Kabat, L. Catherine, K. White, B. Unruh, A. Ramones, In vitro studies of xylitol and erythritol inhibition of Streptococcus mutans and Streptococcus sobrinus growth and biofilm production, J. Clin. Pediatr. Dent. 2020, 44, 307–314.
[8] K. K. Mäkinen, M. Saag, K. P. Isotupa, J. Olak, R. Nõmmela, E. Söderling, P.-L. Mäkinen, Similarity of the effects of erythritol and xylitol on some risk factors of dental caries, Caries Res. 2005, 39, 207–215.
[9] European Commission, Commission regulation (EU) No 432/2012 establishing a list of permitted health claims made on foods, other than those referring to the reduction of disease risk and to children’s development and health, Off. J. Eur. Union 2012, L 136/1.
[10] Y. Park, S. Jeong, J. Zeng, S. Kim, S. Hong, S. Ohk, C. Choi, Anti-cariogenic effects of erythritol on growth and adhesion of Streptococcus mutans, Food Sci Biotechnol 2014, 23, 1587–1588.
[11] E. Hashino, M. Kuboniwa, S. A. Alghamdi, M. Yamaguchi, R. Yamamoto, H. Cho, A. Amano, Erythritol alters microstructure and metabolomic profiles of biofilm composed of Streptococcus gordonii and Porphyromonas gingivalis, Mol. Oral Microbiol. 2013, 28, 435–451.
[12] G. R. Ghezelbash, I. Nahvi, M. Rabbani, Comparative inhibitory effect of xylitol and erythritol on the growth and biofilm formation of oral Streptococci, African J. Microbiol. Res. 2012, 6, 4404–4408.
[13] M. Mensi, A. Cochis, A. Sordillo, F. Uberti, L. Rimondini, Biofilm removal and bacterial re-colonization inhibition of a novel erythritol / chlorhexidine air-polishing powder on titanium disks, Materials (Basel). 2018, 11.
[14] R. Runnel, K. K. Mäkinen, S. Honkala, J. Olak, P. L. Mäkinen, R. Nõmmela, T. Vahlberg, E. Honkala, M. Saag, Effect of three-year consumption of erythritol, xylitol and sorbitol candies on various plaque and salivary caries-related variables, J. Dent. 2013, 41, 1236–1244.
[15] S. Honkala, R. Runnel, M. Saag, J. Olak, R. Nõmmela, S. Russak, P.-L. Mäkinen, T. Vahlberg, G. Falony, K. Mäkinen, E. Honkala, Effect of erythritol and xylitol on dental caries prevention in children, Caries Res. 2014, 48, 482–490.
[16] G. Falony, S. Honkala, R. Runnel, J. Olak, R. Nõmmela, S. Russak, M. Saag, P. L. Mäkinen, K. Mäkinen, T. Vahlberg, E. Honkala, long-term effect of erythritol on dental caries development during childhood: A posttreatment survival analysis, Caries Res. 2016, 50, 579–588.
[17] P. De Cock, K. Mäkinen, E. Honkala, M. Saag, E. Kennepohl, A. Eapen, Erythritol is more effective than xylitol and sorbitol in managing oral health endpoints, Int. J. Dent. 2016, 2016.
[18] N. Müller, R. Moëne, J. A. Cancela, A. Mombelli, Subgingival air-polishing with erythritol during periodontal maintenance: Randomized clinical trial of twelve months, J. Clin. Periodontol. 2014, 41, 883–889.
[19] M. Shimizu, S. Miyawaki, T. Kuroda, M. Umeta, M. Kawabe, K. Watanabe, Erythritol inhibits the growth of periodontal-disease-associated bacteria isolated from canine oral cavity, Heliyon 2022, 8, e10224.
[20] T. Tochio, R. Makida, T. Fujii, Y. Kadota, M. Takahashi, A. Watanabe, K. Funasaka, Y. Hirooka, A. Yasukawa, K. Kawano, The bacteriostatic effect of erythritol on canine periodontal disease–related bacteria, Pol. J. Vet. Sci. 2022, 25, 75–82.
[21] E. K. Dunayer, New findings on the effects of xylitol ingestion in dogs, Vet. Med. 2006, 101, 791–798.
[22] A. K. Eapen, P. de Cock, C. M. Crincoli, C. Means, T. Wismer, C. Pappas, Acute and sub-chronic oral toxicity studies of erythritol in Beagle dogs, Food Chem. Toxicol. 2017, 105, 448–455.
[23] V. Loimaranta, D. Mazurel, D. Deng, E. Söderling, Xylitol and erythritol inhibit real-time biofilm formation of Streptococcus mutans, BMC Microbiol. 2020, 20, 1–9.
[24] S. Kõljalg, I. Smidt, A. Chakrabarti, D. Bosscher, R. Mändar, Exploration of singular and synergistic effect of xylitol and erythritol on causative agents of dental caries, Sci. Rep. 2020, 10, 1–7.
[25] M. Staszczyk, A. Jurczak, M. Magacz, D. Kościelniak, I. Gregorczyk-Maga, M. Jamka-Kasprzyk, M. Kępisty, I. Kołodziej, M. Kukurba-Setkowicz, W. Krzyściak, Effect of polyols and selected dental materials on the ability to create a cariogenic biofilm–on children caries-associated Streptococcus mutans isolates, Int. J. Environ. Res. Public Health 2020, 17, 1–20.
[26] J. Štšepetova, J. Truu, R. Runnel, R. Nõmmela, M. Saag, J. Olak, H. Nõlvak, J. K. Preem, K. Oopkaup, K. Krjutškov, E. Honkala, S. Honkala, K. Mäkinen, P. L. Mäkinen, T. Vahlberg, J. Vermeiren, D. Bosscher, P. De Cock, R. Mändar, Impact of polyols on oral microbiome of Estonian schoolchildren, BMC Oral Health 2019, 19, 1–10.
[27] B. Cvikl, A. Lussi, The biocompatibility of a new erythritol- and xyltol-containing fluoride toothpaste, Healthcare. 2021, 9, 935
** The information contained herein has been compiled carefully to the best of our knowledge. We do not accept any responsibility or liability for the information given in respect to the described product. Full and sole responsibility for use of our products lies with the user, especially in respect to third-party patent rights and to laws or government regulations.
© 2023-039 Jungbunzlauer Suisse AG